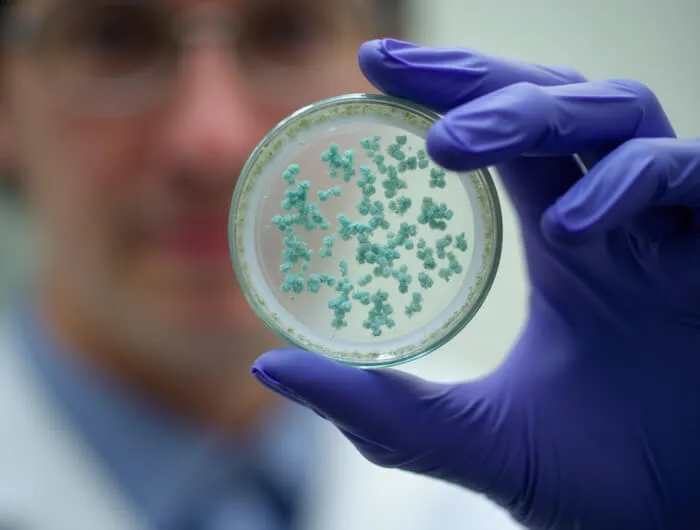
Salud

Health
AIMPLAS provides solutions to the main problems facing companies working in the health industry.
Our solutions for the health sector

-
Production of biocompatible, biodegradable, injectable and resorbable materials (PLA, PCL, PLGA, PLA-PCL…) using various technologies such as synthesis and reactive extrusion.
-
Development of hydrogels for medical applications.
-
Materials for medical 3D printing.
-
Derivatives of natural biopolymers: chitosan, algae, lignin, terpenes, proteins…
-
Development of antimicrobial agents and evaluation of their activity, formulations, and incorporation into different matrices: thermoplastics, resins, coatings.

- Contaminant removal using advanced materials (IAMs): hybrid polymers, carbon-based materials, MOFs, zeolites, 2D materials, biochar, photocatalysts and POPs.
- Separation systems using membranes: PVDF, PES, PA, PC, and biobased membranes such as chitosan, starch or cellulose acetate.
- Purification and extraction processes: isolation of organic molecules using rotary evaporators (up to 50 L), reactors (up to 200 L), automated continuous ultrafiltration, liquid–liquid and solid–liquid extraction, fractional distillation, chromatography, precipitation, crystallisation, and ultracentrifugation.

Development of advanced biosensors: optical, electrochemical, pressure and temperature sensors.
Detection and marking technologies: D-block photoluminescent additives (red light), biobased photoluminescent materials (blue light), isotopically modified materials for infrared detection, and image-based marking technologies (NMR).
Applications in health and the environment: detection of pathogens, diseases, contaminants and drugs through nanoparticle synthesis, receptor functionalisation, immobilisation systems, and development of devices (substrates, inks, membranes, etc.).

- Comprehensive development of medical devices: from conceptual design to validation, including guidance on classification under MDR 2017/745 and material selection in accordance with ISO 10993.
- 3D industrial design and pilot testing: focused on industrial and clinical feasibility, including risk analysis, stability, biocompatibility, safety, usability, and validation.
- Manufacturing processes: thermoplastic injection moulding, tubing extrusion (single-lumen and multi-lumen), and additive manufacturing.
- Medical additive manufacturing: surgical guides, prostheses, orthoses, medical tools, and bioproduction using BioMed resins validated under ISO 18562, ISO 13485 and ISO 10993 for applications involving prolonged contact with skin and mucous membranes.


Advanced contaminant detection:
-
Identification, quantification and characterisation of nano- and microplastics
-
Design of nano- and microplastic standards and extraction methods
-
Analysis of antibiotics, pharmaceuticals and their by-products using chromatographic and spectrometric techniques
Risk assessment through in vitro bioassays:
-
Cell viability and genotoxicity testing
-
Oxidative stress
-
In vitro digestion and intestinal absorption assays
-
Cellular uptake of active compounds
-
Endocrine disruption





















